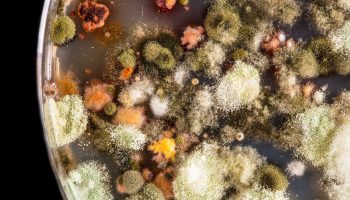

Protect Your Home With Professional Mold Remediation
Believe it or not, mold can occasionally be a good thing. After all, some species of mold are used in the production of antibiotics, foods, and beverages. Unfortunately, the kinds of mold that commonly flourish in homes and businesses are not helpful. These molds range from annoying irritants to dangerous health hazards. Difficult to eradicate … Continue reading Protect Your Home With Professional Mold Remediation